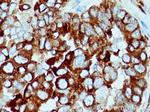
FKBP65 Antibody in Immunohistochemistry (Paraffin) (IHC (P))

Search
Proteintech
FKBP65 Polyclonal Antibody
{{$productOrderCtrl.translations['antibody.pdp.commerceCard.promotion.promotions']}}
{{$productOrderCtrl.translations['antibody.pdp.commerceCard.promotion.viewpromo']}}
{{$productOrderCtrl.translations['antibody.pdp.commerceCard.promotion.promocode']}}: {{promo.promoCode}} {{promo.promoTitle}} {{promo.promoDescription}}. {{$productOrderCtrl.translations['antibody.pdp.commerceCard.promotion.learnmore']}}
产品信息
12172-1-AP
种属反应
已发表种属
宿主/亚型
分类
类型
抗原
偶联物
形式
浓度
规格
纯化类型
保存液
内含物
保存条件
运输条件
产品详细信息
Immunogen sequence: PFLAYGEKG YGTVIPPQAS LVFHVLLIDV HNPKDAVQLE TLELPPGCVR RAGAGDFMRY HYNGSLMDGT LFDSSYSRNH TYNTYIGQGY IIPGMDQGLQ GACMGERRRI TIPPHLAYGE NGTGDKIPGS AVLIFNVHVI DFHNPADVVE IRTLSRPSET CNETTKLGDF VRYHYNCSLL DGTQLFTSHD YGAPQEATLG ANKVIEGLDT GLQGMCVGER RQLIVPPHLA HGESGARGVP GSAVLLFEVE LVSREDGLPT GYLFVWHKDP PANLFEDMDL NKDGEVPPEE FSTFIKAQVS EGKGRLMPGQ DPEKTIGDMF QNQDRNQDGK ITVDELKLKS DEDEERVHEE L (233-582 aa encoded by BC016467)
靶标信息
MAF acts as a transcriptional activator or repressor. The protein is involved in embryonic lens fiber cell development.
仅用于科研。不用于诊断过程。未经明确授权不得转售。
生物信息学
蛋白别名: 65 kDa FK506-binding protein; 65 kDa FKBP; FK506 binding protein 10, 65 kDa; FK506 binding protein 6 (65 kDa); FK506-binding protein 10; FKBP-10; FKBP-65; Immunophilin FKBP65; osteognesis imperfecta with congenital joint contractures; Peptidyl-prolyl cis-trans isomerase FKBP10; peptidyl-prolyl isomerase; Pfam PF00254; PPIase FKBP10; Rotamase; Telopeptide lysyl hydroxylase, bone-specific; unnamed protein product
基因别名: AI325255; BRKS; BRKS1; FKBP-10; FKBP-65; Fkbp-rs; Fkbp-rs1; Fkbp1-rs; FKBP10; Fkbp6; FKBP65; Fkbprp; hFKBP65; OI11; OI6; PPIASE; PSEC0056; TLH1
UniProt ID: (Human) Q96AY3, (Mouse) Q61576
Entrez Gene ID: (Human) 60681, (Mouse) 14230